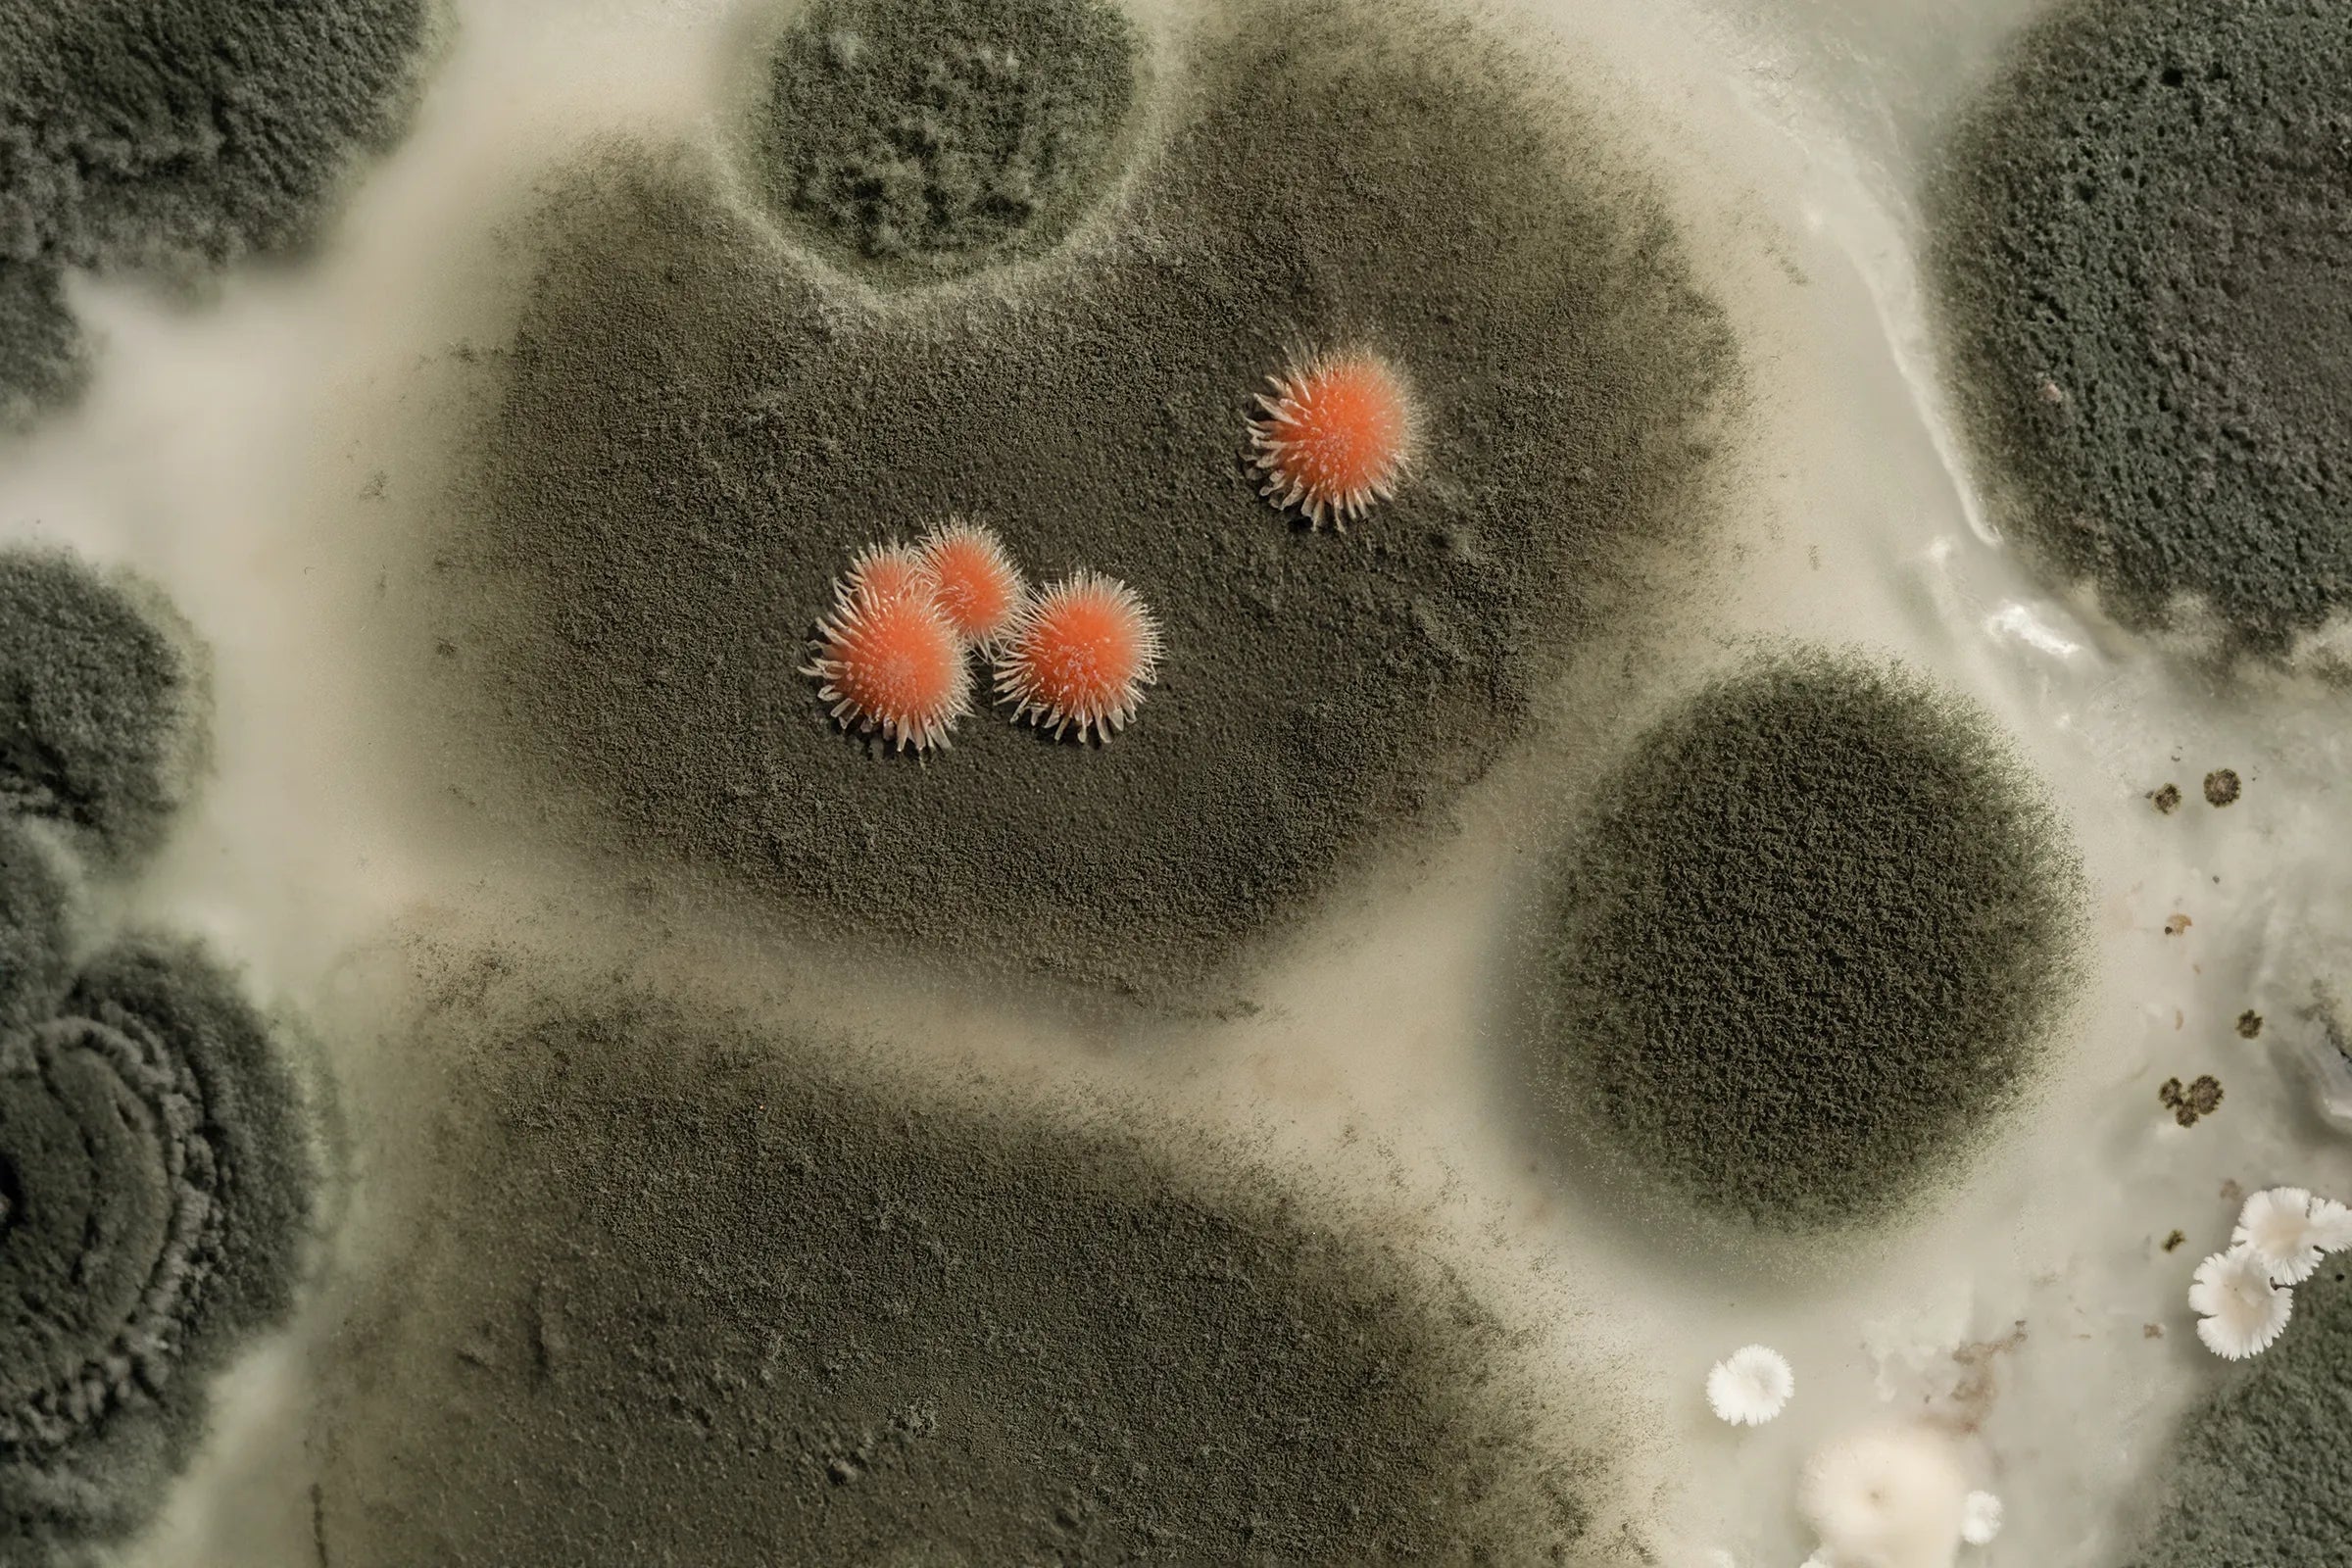
Dry It Center

Equip your business with the best
We support restoration and cleaning professionals with the high-performance equipment, chemicals, and supplies they rely on every day. Whether you run a carpet cleaning business, a mitigation team, or a multi-crew operation, we offer bulk pricing, pro-grade bundles, fast service, and dependable repair support to keep your business moving. Our focus is simple: provide the tools, reliability, and expertise that help you deliver exceptional results—job after job.
Get access to curated tools, specialized product collections, and pro-focused resources designed to streamline your workflow and strengthen your operations. From smarter purchasing options to equipment support and industry-specific solutions, this hub helps you equip your team with exactly what they need to stay efficient and competitive.
Pro-only Product Bundles
Rentals
Get the right gear fast—rent pro equipment for daily, weekly, or emergency needs
Air Quality & Safety BLog
Understanding Airborne Mold Spores After Water Damage
Mold isn’t always visible — tiny airborne spores can linger after water damage and affect your home’s air quality. Learn how mold spreads, why it matters for your health, and when to tackle it yourself versus calling a professional.
Read moreAir Quality After Water Damage: When an Air Scrubber Helps
Air Quality After Water Damage: When an Air Scrubber Helps How to Know If One Is Right for Your Situation After water damage, cleanup, or demolition, most people focus on what they can see — wet floors, torn-out materials, or debris. What often gets overlooked is what’s floating in the air. That’s where an air scrubber becomes important. What an Air Scrubber Does An air scrubber is a portable filtration system that removes airborne particles from an enclosed space. Depending on the filters used, it can capture: Dust and debris Mold spores Bacteria Allergens Odors (with carbon filtration) Air scrubbers are designed for restoration and construction environments, where air quality can quickly decline. Situations Where an Air Scrubber Is Recommended You should consider using an air scrubber if: You smell musty or mold-like odors Mold is visible or suspected Wet or damaged materials are being removed The water source was contaminated Someone in the home has asthma, allergies, or sensitivities Running an air scrubber during these situations helps reduce airborne particles and prevents contaminants from spreading to unaffected areas. When an Air Scrubber May Not Be Necessary An air scrubber may not be needed if: The water damage was very small and dried quickly No materials were disturbed or removed There are no odors or signs of mold Drying was limited to surface moisture only Final Thought If drying equipment handles the water, an air scrubber handles the air. It’s a smart layer of protection when air quality is a concern — especially during drying, cleanup, or demolition.
Read more

![[RENTAL] Pro-Dri Laminar Air Mover Rental – 2.9 Amp Low-Profile Dryer](http://dryitcenter.com/cdn/shop/files/AirMover-Laminar-2.9Amp.webp?v=1722027099&width=900)
![[RENTAL] Pro-Dri Laminar Air Mover Rental – 2.9 Amp Low-Profile Dryer](http://dryitcenter.com/cdn/shop/files/pro-dri-2-9-amp-air-mover-feature-callout.webp?v=1750976495&width=2048)
![[RENTAL] Pro-Dri 90-Pint Suitcase Dehumidifier Rental – Compact & Powerful](http://dryitcenter.com/cdn/shop/files/ProDricompactdehu_ef812618-e1ab-4652-a307-c5fe5d513afc.png?v=1722027503&width=1652)
![[RENTAL] Mytee Spyder Cleaner/Extractor – Compact Heated Carpet Extractor](http://dryitcenter.com/cdn/shop/files/myteespyderfront.png?v=1722962893&width=854)
![[RENTAL] Pro-Dri 500 CFM Air Scrubber – Professional Grade Filtration](http://dryitcenter.com/cdn/shop/files/AirScrubber.jpg?v=1722027346&width=1433)
![[RENTAL] Total Zone Ozone Generator Rental – Odor Neutralizer for Restoration & Cleaning](http://dryitcenter.com/cdn/shop/files/OzoneGenerator.jpg?v=1722029570&width=2000)
![[RENTAL] PMF 12" Carpet Cleaning Wand](http://dryitcenter.com/cdn/shop/files/pmf-12in-hard-surface-wand-800psi_2378829f-3272-4b86-a5e9-b4c60351b8be.png?v=1752173652&width=1024)
![[RENTAL] Phoenix R-200 125-Pint Stand-Up Dehumidifier – Commercial Drying Unit](http://dryitcenter.com/cdn/shop/files/Dehumidifier_StandUp_90AHAM.webp?v=1722027448&width=1419)
![[RENTAL] Mytee Air Hog Extractor – High-Powered Water Recovery](http://dryitcenter.com/cdn/shop/files/MyteeAirHog_ccd08dbf-298f-4463-be4e-1d4e5ba46423.jpg?v=1722029436&width=600)

